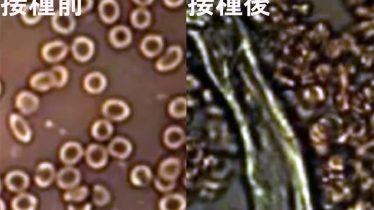

コロナワクチン
コロナワクチン 東京の新規感染1308人は…最悪試算「8月上旬4000人」を上回る衝撃のハイペース
東京の新規感染1308人は…最悪試算「8月上旬4000人」を上回る衝撃のハイペース8月10日ごろには4000人になると試算!「8月上旬に4000人」との最悪のケース(試算)を上回るペースだ。15日の東京の新規感染者は1308人。急峻な上り坂...
 コロナワクチン
コロナワクチン  コロナワクチン
コロナワクチン コロナワクチン
コロナワクチン  コロナワクチン
コロナワクチン  アセンション
アセンション  アセンション
アセンション